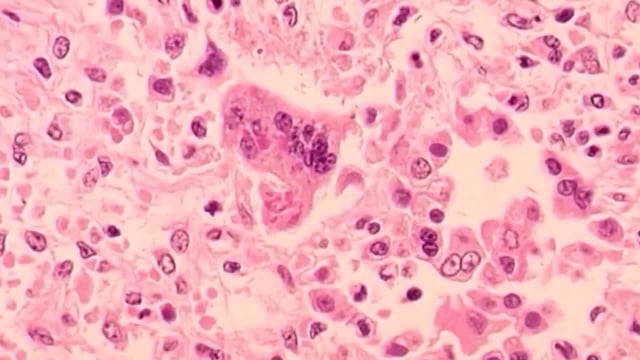

Overview
- Twin Cities International Schools reported a student case confirmed by the Minnesota Department of Health, and the school says it is following MDH guidance and implementing safety measures.
- Since Sept. 29, MDH has confirmed 10 new cases in the Twin Cities metro, bringing the year’s total to 18 statewide.
- Officials say seven of the new cases involve families with recent domestic travel linked to three earlier cases, and three involve international travel.
- All identified patients are unvaccinated, and MDH is urging families to get children up to date on MMR shots and to consult clinicians before travel to outbreak areas.
- U.S. measles cases have surpassed 1,500 this year, the most since 1992, with a major West Texas outbreak reporting 762 cases and three deaths, while Minnesota’s kindergarten MMR coverage stands at about 86.5%.